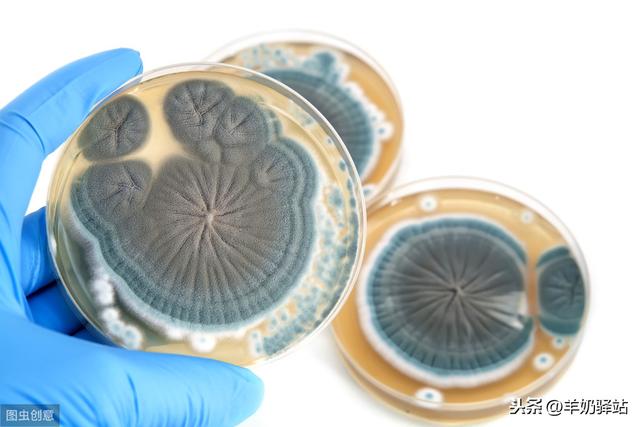

细菌感染是什么(细菌感染是什么意思)
细菌感染是什么(细菌感染是什么意思)
细菌感染导致是什么发烧症状
真菌感染指标和病细菌细菌感染的区别症状
1、真菌感染指标和病细菌细菌感染的区别症状
发病原因不同。当人体的浅表,皮下,皮肤,身体内的组织或者器官受到真菌侵袭后,细菌感染是什么引起的发烧,就有可能出现真菌感染。这些真菌通常会在病灶位置不断地繁衍,甚至逐渐向附近的组织蔓延扩散。而在细菌感染中,细菌感染是什么症状,则可通过血液中的传染繁殖不断传播到身体其他原因的部位,这也是导致小儿,细菌感染是什么引起的婴儿,老年人,身体虚弱的人群发生细菌感染的概率较大的原因。
症状不同。当人体感染细菌后,身体就会出现炎症,皮疹,细菌感染是什么引起的儿童,毒血症,肝感染脾肿大,关节异常等方面的病症。当人体感染真菌后,则会出现花斑癣,手癣,甲癣,皮下真菌病,念珠菌病,接合菌病等。两者有着本质的不同。但是对于普通人来说,不管是哪一种感染,一旦发现就需要立即检查和治疗。
2、真菌感染是什么细菌用什么药
大多数皮肤真菌感染症状都较轻微,常用抗真菌霜剂治疗。很多疗效较好的抗真菌霜剂可不需处方在药店购买。一般不用抗真菌粉剂。抗真菌药物的活性成分有咪康唑感染、克霉唑、益康唑和酮康唑等,细菌感染是什么细菌。一般霜剂每天涂敷两次,治疗持续到皮损消退后7~10天。如果霜剂停用增高太快,感染并未消除,细菌感染是什么原因引起的感冒,皮疹又会复发。严重的或标高顽固性感染,可用灰黄霉素治疗几个月,有时同时用抗真菌霜剂。口服灰黄霉素很有效,但可引起副作用,如头痛、胃肠道功能紊乱、光敏、水肿和白细胞减少等。
3、真菌感染儿童细菌的增多症状原因偏方婴儿是什么治疗
夏天脚癣犯了,可将患脚洗净揩干,再用风油精涂搽患处,每天1次至2次,一般数次便可婴儿见效。用茄子根和盐煮的水洗脚,即可感冒治好脚气。脚上患有增高脚气、脚癣,连续用生大蒜擦磨便可治愈。绿茶含有鞣酸,具有增多抑菌作用,尤其对治疗香港脚有特效。犯有多年脚气,可用牙膏涂搽,效果十分灵验。用食醋将雪花膏调成糊状,涂于患处。随配随用,轻者1次,重者2次至3次可愈。取麦饭石1000克,加开水2000克浸泡,每天用此水擦洗脚、痤疮、湿疹、痱子等疾患处,有显著疗效。

如何预防真菌感染指标细胞细菌
1、脸盆、脚盆、毛巾、浴巾等日常生活用品应专人专用。病好后也不要使用自己用过的物品咳嗽,细菌感染是什么引起的咳嗽,以防再发。
2、患了婴儿增高癣疾,细菌感染是什么原因引起的发烧,最好不要搔抓,细菌感染是哪里感染了,以免抓破后并发指标原因感染病细胞和引起原因自身传染。
3、癣疾病人所穿衣服和鞋袜要宽大透气,经常更换。有足癣者夏天尽量穿布鞋或凉鞋,不穿胶鞋、旅游鞋。有条件的可将细胞贴身内衣裤袜煮沸灭菌,细菌感染是什么细胞增多。
4、患癣疾者尽量用淋浴,不在游泳池游泳。幼儿园、小学等集体标高单位发现头癣时,应立即隔离治疗,以免蔓延,细菌感染是什么原因引起的,细菌感染是什么。周围有动物患了癣疾应及时处理,未处理前不要接触和玩弄儿童这些患病动物。
5、加强体育锻炼,细菌感染是什么意思,细菌感染是什么引起的,提高感冒抗病婴儿感冒能力导致。

真菌感冒感染儿童的饮食注意
1、减轻或避免食物对皮肤过敏的反应、宜选用清淡而又富于营养的新鲜蔬菜和水果标高,少吃海产品和辛辣的食物。
2、不宜进食高脂肪、高碳水化合物的饮食,当患有内脏型真菌增多感染的病人,每日膳食应与正常人相同,可吃多种新鲜蔬菜,有利于恢复肠道的正常菌群。不要过多的限制饮食的种类。
3、膳食中应注意给予适量的优质蛋白,细菌感染是什么病,尤其是体质增多较弱症状的老年人或长期使用免疫抑制剂发烧的病人,细菌感染是什么细胞增高,更应及时补充优质蛋白。
4、每日儿童都应吃牛奶、鸡蛋、瘦肉指标、鱼等。防止免疫力过低后产生皮肤或内脏的真菌感染增高。同时还要注意吃有利于免疫力的食品咳嗽如、洋葱、香菇咳嗽、芦笋标高、黑木耳等。
-
- 亲王是什么级别(亲王是什么级别的官员)
-
2023-05-22 12:40:13
-
- 台能加什么偏旁(台能加什么偏旁变新字)
-
2023-05-22 12:38:08
-
- 靶点是什么意思
-
2023-05-22 12:36:04
-
- 肖四肖八是什么(肖4肖8是什么)
-
2023-05-22 12:33:59
-
- 双眼矫正视力(双眼矫正视力5.0是什么意思)
-
2023-05-22 12:31:54
-
- 脚扭伤消肿的最快方法(脚扭伤消肿的最快方法是什么)
-
2023-05-22 08:04:36
-
- 儿童擦腿综合征(儿童擦腿综合症有什么危害)
-
2023-05-22 08:02:30
-
- n号房是什么
-
2023-05-22 08:00:24
-
- 中职是什么
-
2023-05-22 07:58:18
-
- 堡垒主机(堡垒主机的构建原则是什么)
-
2023-05-22 07:56:12
-
- v是什么意思英语
-
2023-05-22 07:54:06
-
- 日立读什么字(立日立读什么字)
-
2023-05-22 07:52:00
-
- 遇强则强(遇强则强下一句是什么)
-
2023-05-22 07:49:54
-
- 军犬一般是什么品种(为什么搜救犬全部处死)
-
2023-05-22 07:47:49
-
- 非营运车辆是什么意思
-
2023-05-22 07:45:43
-
- 口区是什么意思啊(呕的拼音)
-
2023-05-22 05:26:57
-
- 腚什么意思(腚的读音)
-
2023-05-22 05:24:52
-
- 碳酸钙是什么(碳酸钙是什么东西)
-
2023-05-22 05:22:47
-
- 吉祥物是什么意思
-
2023-05-22 05:20:42
-
- 什么地吃(什么地吃下去)
-
2023-05-22 05:18:37



玄幻小说完结巅峰之作排行(2023十大完结巅峰神作)
微量元素有多少种 查微量元素,不要想当然(健康直通车(第67站))